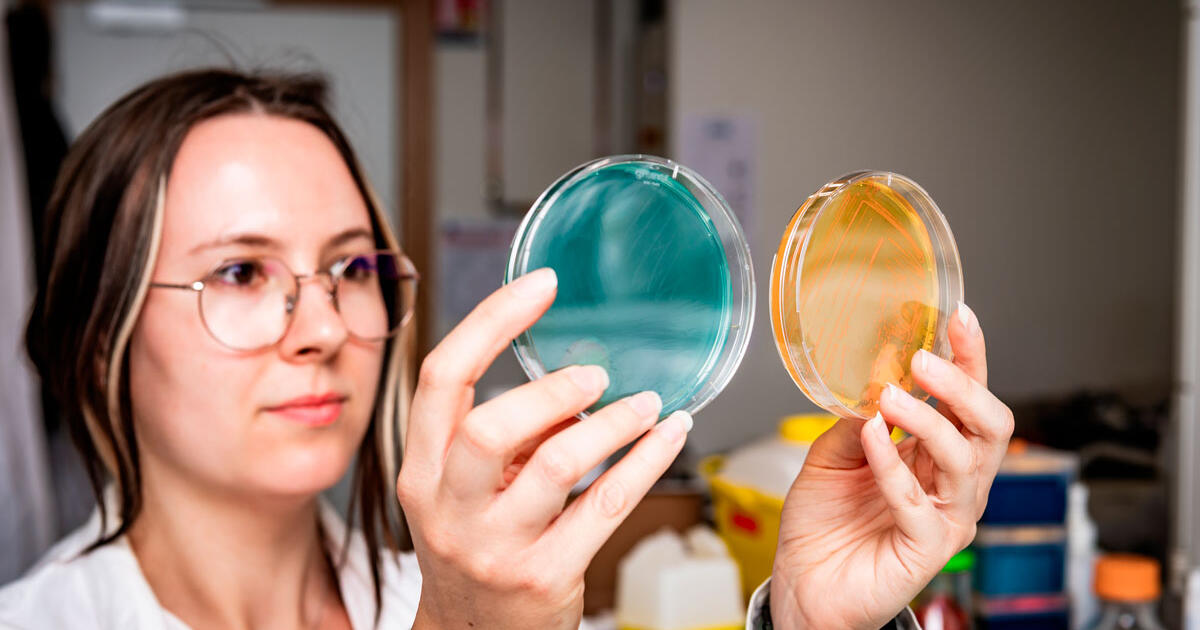
"Forever chemicals" could see their days numbered

The ubiquitous squeak of sneakers on a basketball court may be caused by more than just friction, a new study suggests.
Researchers have found that the sharp chirp of rubber on a hard floor happens when tiny areas of slipping between the shoe’s…

The ubiquitous squeak of sneakers on a basketball court may be caused by more than just friction, a new study suggests.
Researchers have found that the sharp chirp of rubber on a hard floor happens when tiny areas of slipping between the shoe’s…

February 25, 2026
2 min read
Add Us On GoogleAdd SciAm
Nobel Prize–winning brain scientist steps down over Epstein ties
Richard Axel resigned from his post co-leading Columbia University’s Mortimer B. Zuckerman Mind Brain Behavior Institute over…

A strange cosmic outburst might just provide the first direct evidence of an intermediate-mass black hole feeding on a white dwarf star. Discovered by the China-led Einstein Probe space telescope in July 2025, this event could open a window…

Astronomers have made an exciting discovery in the search for distant exoplanets. A new super-Jupiter, nearly five times the mass of our own Jupiter, has been found orbiting the star TIC-65910228, a metal-rich sun-like star located 864 light…
Many everyday objects contain PFAS, synthetic molecules that are virtually indestructible. These thousands of compounds are accumulating in both nature and our organisms. One avenue for eradicating them is bioremediation, which eliminates…

The 190-million-year-old newly discovered ichthyosaur fossil, nicknamed the “Sword Dragon of Dorset,” features a remarkably well-preserved skeleton. Its nearly complete remains have opened a window into a transformative period in…

Many people assume that medicines sold over the counter are inherently safe. After all, if you can buy something in a supermarket or high street pharmacy, how dangerous can it really be?
The reality is more complicated. Several commonly used

Heating accounts for nearly half of our global energy demand. Right now, we meet two-thirds of that demand by burning fossil fuels.
Solar power offers a cleaner path. We install panels and…

February 25, 2026
2 min read
Add Us On GoogleAdd SciAm
Astronomers spot a young sun blowing bubbles inside the Milky Way
A baby sunlike star blowing a bubble of hot gas called an “astrosphere” was captured for the first time by NASA’s Chandra…